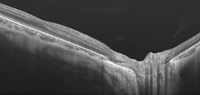

Volumen 22 - Número 5 - Diciembre 2014
Bases y sistemas de la tomografía óptica de coherencia
J. Zarranz-Ventura1,2, PA. Keane2
1Unidad de Vítreo-Retina. Institut Clínic d’Oftalmologia (ICOF). Hospital Clínic. Barcelona.
2NIHR Biomedical Research Centre for Ophthalmology. Moorfields Eye Hospital NHS Foundation Trust and UCL Institute of Ophthalmology. Londres. Reino Unido.
2NIHR Biomedical Research Centre for Ophthalmology. Moorfields Eye Hospital NHS Foundation Trust and UCL Institute of Ophthalmology. Londres. Reino Unido.
CORRESPONDENCIA
Javier Zarranz-Ventura
E-mail: jzarranz@hotmail.com
E-mail: jzarranz@hotmail.com
Introducción - Principios básicos de tomografía óptica de coherencia (OCT)
La tomografía óptica de coherencia (OCT) es un método de imagen ocular análogo a los ultrasonidos, pero que mide las ondas de luz reflejadas en vez de las ondas de sonido1. En esta técnica, la combinación de la luz reflejada de un tejido de interés y la luz reflejada de un brazo de referencia conocido produce patrones característicos de interferencia dependientes de la diferencia entre ambas ondas reflejadas. Dado que el retraso (delay) y la amplitud de una de las ondas (la del brazo de referencia) son conocidos, el retraso y la intensidad de la luz reflejada del tejido pueden ser extraídos del patrón de interferencia. Como la longitud de onda de la luz es mucho más corta que la del sonido, las OCT generan imágenes de resolución considerablemente superior a los ultrasonidos o ecografías (por ejemplo con una resolución axial de 3-8 µm en los dispositivos comerciales habituales).OCT de dominio tiempo (time domain) y dominio espectral (spectral domain)
En los primeros sistemas de OCT, los patrones de interferencia generados variaban en una función de tiempo empleando un espejo móvil en el brazo de referencia; a estos dispositivos se les conoce genéricamente como OCT de dominio tiempo (time domain OCT)1. En otros dispositivos más recientes, los patrones de interferencia generados se miden como una función de frecuencia, empleando un espectrómetro que sigue el principio de Fourier; de ahí el nombre de OCT de dominio espectral (spectral domain OCT). La principal ventaja de estos dispositivos es que eliminan la necesidad de mover físicamente un espejo de referencia, posibilitando una velocidad de captura de imágenes muy superior en comparación con las anteriores OCT de dominio tiempo. Por ejemplo, los sistemas de dominio tiempo (como Stratus OCT, Carl Zeiss Meditec, Alemania) tienen una velocidad de captura de imágenes de 400 scans en modo A por segundo, mientras que los sistemas de dominio espectral (3D OCT, Topcon; Cirrus HD-OCT, Carl Zeiss Meditec; Spectralis OCT, Heidelberg Engineering) tienen una velocidad de captura de 20.000 scans en modo A por segundo. Como resultado de estas diferencias en la velocidad de captura, es posible obtener un número mucho mayor de scans en modo A en un mismo tiempo de examinación, permitiendo una mejor resolución de las imágenes, además de cubrir un área de escaneo más amplia (por ejemplo, 128 scans en modo B en un patrón horizontal cubriendo un área de 6 mm). Esta mayor área de escaneo reduce la posibilidad de cometer errores, haciendo más difícil pasar por alto áreas de patología focal que quizá con una menor densidad de escaneo o scans lineales pudieran no ser detectadas (Figura 1).
Figura 1. Diferencia en resolución de imágenes de OCT de dominio tiempo y espectral. (A) Imagen con OCT de dominio tiempo (Stratus OCT-3, Carl Zeiss Meditec, Dublin, CA, USA). (B) Mismo ojo escaneado a continuación con OCT de dominio espectral (Cirrus HD-OCT, Carl Zeiss Meditec, Dublin, CA, USA). La mayor velocidad de escaneo con el dispositivo de dominio espectral permite obtener una mayor cantidad de scans en modo A en una única captura, que a continuación son promediados por el software integrado en el dispositivo permitiendo obtener imágenes de una mayor resolución. Esto hace posible analizar detalles con precisión, como estos quistes intraretinianos no detectados en la imagen obtenida con el dispositivo de dominio tiempo. Además, esta mayor velocidad de escaneo hace que sea posible cubrir áreas más amplias en prácticamente el mismo tiempo de captura, disminuyendo el riesgo de pasar por alto detalles focales no capturados en scans lineales únicos.
Swept Source OCT´s - OCT de longitud de onda larga (long-wavelength OCTs)
Como ya se ha comentado, los dispositivos de dominio espectral analizan patrones de interferencia como función de frecuencia mediante el uso de un espectrómetro (las ondas de luz que inciden en el espectrómetro en primer lugar se dispersan mediante una rejilla de difracción [diffraction grating] y son analizadas después con una cámara CCD). Un método alternativo para la evaluación de estos patrones de interferencia es el uso de un laser cuya frecuencia es “ajustable” como fuente de luz, sistema denominado swept-source1. La nueva generación de sistemas de OCT comerciales es la que emplea esta tecnología, cuyos primeros ejemplos son el DRI-OCT-1, “Atlantis” (Topcon, Japón) para imagen retiniana y el CASIA OCT SS-1000 (Tomey, Japón) para imágenes de segmento anterior (Figura 2).

Figura 2. Imágenes de OCT con tecnología swept-source. (A) DRI-OCT-1 Atlantis (Topcon, Japón). Paciente con coriorretinopatía serosa central. Debido a la mayor velocidad de escaneo del aparato, el número de scans en modo A obtenidos en una única captura es mucho mayor, permitiendo una vez procesados obtener una imagen de alta calidad. Del mismo modo, debido a la mayor penetración del laser de 1050 nm se aprecian detalles del límite de la coroides externa, cubriendo un área de escaneo más grande, de hasta 12 mm, incluyendo el área de la cabeza del nervio óptico y la retina temporal a la fóvea en una única imagen. (Fuente: http://www.topcon.co.jp/en/eyecare/product/diag/oct/dri_oct-1.html) (B) CASIA OCT SS-1000 (Tomey, Japón). La tecnología swept-source permite obtener imágenes tridimensionales del segmento anterior en una única captura con una resolución axial de 10 micras y una resolución transversal de 30 micras. (Fuente: http://www.tomey.com/Products/OCT/SS-1000CASIA.html).
Estos dispositivos swept-source tienen el potencial de aumentar todavía más la velocidad de adquisición de imágenes. El dispositivo DRI-OCT-1 tiene una velocidad de adquisición de imágenes de 100.000 scans en modo A por segundo. Dado que la motilidad ocular limita el tiempo de adquisición de imágenes en la práctica clínica habitual, esta mejoría en el tiempo de captura posibilita el escaneado de áreas mucho mayores de tejido (por ejemplo 12 x 9 mm en el caso del DRI-OCT en comparación con 6 x 6 mm con el 3D OCT o el Cirrus OCT) e incluso una reconstrucción tridimensional completa del polo posterior. Existen prototipos en fase de investigación con velocidades de captura de imágenes aún mayores. Por ejemplo, se han descrito velocidades de adquisición de imágenes de 6.700.000 scans en modo A por segundo, utilizando un OCT swept-source con un laser de haz dual de dominio Fourier en modo fijo (Fourier-domain mode-locked)2. De llegar a emplearse en la práctica clínica habitual aparatos con velocidades de captura de esta magnitud, por primera vez se podrían obtener imágenes de OCT para aplicaciones como guía intraoperatoria en vídeo en tiempo real3.
Los sistemas de OCT swept-source están capacitados además para incorporar fuentes de luz de longitud de onda larga (long-wavelength OCT light sources)4. Hasta la fecha, los dispositivos de OCT comerciales han empleado fuentes de luz del rango de 800 a 900 nm. Aunque las imágenes obtenidas con estas fuentes de luz proporcionan una visualización excelente de la arquitectura retiniana, frecuentemente no es posible obtener detalles de las estructuras y anomalías más allá del epitelio pigmentario de la retina. Sin embargo, la adquisición de imágenes de OCT con fuentes de luz de mayor longitud de onda (por ejemplo, del orden de 1000 nm o más) permite una mayor penetración de la luz para la visualización de estructuras profundas. Por ello, los sistemas de OCT de longitud de onda larga abren nuevas posibilidades para evaluar in vivo la coroides, la esclera e incluso la cabeza del nervio óptico. De hecho, en pacientes con miopía magna y adelgazamiento de las capas retinianas y coroideas puede incluso visualizarse la grasa orbitaria bajo la esclera y el espacio subaracnoideo alrededor del nervio óptico (Figura 3).
Figura 3. Imagen obtenida con el DRI-OCT-1 Atlantis (Topcon, Japón). En la miopía magna, el adelgazamiento de las capas retinianas y coroideas hace posible la penetración del haz de luz del laser de 1050 nm hasta capas profundas, pudiéndose apreciar detalles anatómicos de la esclera y la cabeza del nervio óptico, e incluso en casos seleccionados la grasa orbitaria y el espacio subaracnoideo. (Fuente: http://www.topcon.co.jp/en/eyecare/product/diag/oct/dri_oct-1.html).
Dispositivos OCT portátiles y OCT intraoperatoria
La mayoría de los dispositivos de OCT son diseñados para su montaje en formato mesa, permitiendo al clínico mover y orientar el instrumento mientras la cabeza y los ojos del paciente permanecen estables en una mentonera. Esto es posible en la gran mayoría de los pacientes, con el principal y casi único requisito de que el paciente debe ser capaz de deambular y cooperar para mantener la postura que permita la captura de imágenes. Para solucionar casos en los que esto no es posible se han propuesto varios dispositivos con construcciones alternativas5. Por ejemplo, Bioptigen ha desarrollado dispositivos de OCT de dominio espectral como el Envisu C-class (Bioptigen, Morrisville, NC, USA), que consta de un cabezal manejable de forma manual unido por una sonda de 1,3 metros a una consola central en soporte mesa (similar a los dispositivos de ecografía) (Figura 4A). Este dispositivo ha sido evaluado ampliamente en unidades de cuidados intensivos neonatales, consultas de oftalmología pediátrica, investigación en animales y sistemas de imagen intraoperatoria. Específicamente, se ha demostrado útil en neonatos para el estudio del desarrollo ocular y en enfermedades como la retinopatía del prematuro. El sistema iVue de dominio espectral (Optovue, Fremont, CA, USA) es otro dispositivo aprobado por la Food and Drug Administration americana que también combina una unidad de base compacta con un cabezal de escaneado móvil (Figura 4B).
Figura 4. Dispositivos portátiles de OCT. (A) Envisu C-class (Bioptigen, Morrisville, NC, USA). Consta de un cabezal portátil unido a una consola central por una sonda de 1,3 metros. Se ha evaluado su uso en unidades de cuidados intensivos neonatales para la evaluación de la retinopatía del prematuro, así como en consultas de adultos con problemas de movilidad. (Fuente: http://www.bioptigen.com/products/c-class/) (B) iVue (Optovue, Fremont, CA, USA). El dispositivo iVue permite manejar el cabezal de captura de forma manual, existiendo plataformas compactas específicas, como el iStand (derecha), dotadas de ruedas para una mayor movilidad del sistema que permite evaluar pacientes encamados. (Fuente: http://optovue.com/products/ivue/).
El uso de OCT intraoperatoria es quizá la aplicación futura más importante de estos sistemas, con aplicaciones potenciales en las áreas de córnea (por ejemplo la queratoplastia lamelar y otros procedimientos de trasplantes corneales), cirugía de cataratas (implante y alineamiento de lentes tóricas), cirugía de glaucoma (trabeculectomías y otros procedimientos filtrantes) y cirugía de vítreo-retina (pelado de membranas epirretinianas y cirugías de agujero macular). Sin embargo, una limitación significativa de los sistemas comercialmente disponibles en la actualidad es la necesidad de mover el dispositivo dentro y fuera del campo quirúrgico durante el procedimiento. Las casas comerciales Bioptigen, Carl Zeiss Meditec y algunas otras están desarrollando la próxima generación de sistemas de OCT intraoperatoria, en los que la vía óptica del sistema de OCT irá incorporada al microscopio quirúrgico (microscope-incorporated OCT, MI-OCT)6. Esto eliminará la necesidad de mover el dispositivo dentro y fuera del campo quirúrgico, facilitando su uso intraoperatorio. Los sistemas MI-OCT deberán ser parfocales y coaxiales, de modo que las imágenes de OCT sean capturadas de forma “automática” sin necesidad de ajustar el foco o la magnificación de las imágenes, o la propia posición del microscopio. En la actualidad existen prototipos experimentales de OCT intraoperatoria integrada en los microscopios quirúrgicos que incorporan sistemas de ajuste y enfoque eléctricos, y además permiten aplicar la tecnología en-face para estimar la distancia de los instrumentos a la retina en códigos de colores, como por ejemplo en el pelado de membranas epiretinianas (Figura 5)7. El desarrollo de estos sistemas hará que la ayuda proporcionada por la OCT intraoperatoria sea cada vez mayor, y caben esperar mejoras en los próximos años tanto en lo que respecta a las pantallas de visualización de imágenes de OCT integradas en los microscopios como en el desarrollo de instrumentos quirúrgicos específicos, con propiedades ópticas determinadas que produzcan una disminución de la sombra posterior en las imágenes de OCT.
Figura 5. OCT intraoperatoria con sistema de autofoco eléctrico y tecnología en-face. La superficie del pincel de pelado aparece codificada en rojo y la membrana limitante de la retina en verde en las imágenes de OCT (arriba y derecha). La diferencia de posición axial entre ambas estructuras permite obtener una medida de la distancia entre el instrumento y la retina, y con ayuda de la tecnología en-face se representa en un código de colores visible en el propio instrumento, ofreciendo esta información al cirujano durante el pelado y facilitando las maniobras quirúrgicas (izquierda). (Fuente: Tao YK, Srivastava SK, Ehlers JP. Microscope-integrated intraoperative OCT with electrically tunable focus and heads-up display for imaging of ophthalmic surgical maneuvers. Biomedical Optics Express. 2014;5(6):1877-85).
Angiografía de coherencia óptica
Un foco importante de investigación en OCT en la actualidad es la generación de mapas tridimensionales de la vascularización retiniana y coroidea, en lo que ha venido a llamarse angiografía de coherencia óptica (optical coherence angiography, OCA). Existen varios tipos de técnicas de OCA en desarrollo8,9. Esencialmente, estas técnicas están basadas en la adquisición secuencial a alta velocidad de imágenes de OCT en modo A y B en un mismo foco determinado de la retina, extrayendo después las diferencias entre los scans que suceden a consecuencia del flujo sanguíneo con un algoritmo denominado SSADA (split-spectrum amplitude-decorrelation angiography)9. Mientras en la tecnología Doppler OCT la medida de los cambios de fase entre los scans en modo A permite la generación de contraste, en las OCT de contraste de fase (phase-contrast OCT) la medida de las diferencias en los scans en modo B secuenciales permite la detección de movimiento (por ejemplo flujo sanguíneo). Tras la adquisición de imágenes de OCA es posible generar mapas tridimensionales del árbol vascular retinocoroideo, o imágenes del fondo de ojo en 2D con códigos de colores de la profundidad de los vasos (Figura 6).

Figura 6. Angiografía de coherencia óptica (OCA). Combinando una plataforma OCT de swept source y un algoritmo de procesado de imágenes denominado SSADA (split-spectrum amplitude-decorrelation angiography) se puede evaluar el flujo a distintos niveles retinocoroideos sin la inyección de contraste, obteniendo imágenes de lo que se conoce como angiografía 3D. En el ejemplo de la imagen, publicado por el grupo del Dr. David Huang, se aprecia una neovascularización coroidea tipo 2 (clásica) perfectamente delimitada entre el epitelio pigmentario y la retina, con imágenes secuenciales a distintos planos, a nivel de la retina interna (D), la retina externa (E) y la coriocapilar-coroides interna (F). Además, es posible representar el nivel al que se encuentra la lesión en cortes convencionales (G y H), así como hacer reconstrucciones en 2D (J). (Fuente: Jia Y, Bailey ST, Wilson DJ, et al. Quantitative optical coherence tomography angiography of choroidal neovascularization in age-related macular degeneration. Ophthalmology. 2014;121(7):1435-44).
Esta técnica abre un abanico de posibilidades apasionante al permitir combinar esta tecnología con otros métodos como la oftalmoscopia con escaneado laser y técnicas de ópticas adaptativas (adaptive optics-scanning light ophthalmoscope, AO-SLO). La incorporación de esta técnica a la tecnología OCA permitirá generar mapas vasculares de la retina y la coroides con la alta resolución axial de la OCA y la alta resolución transversal de la AO-SLO. De hecho, el primer prototipo que combina ambas técnicas ya ha sido descrito10.
Medida del flujo sanguíneo mediante OCT - Doppler OCT
En la actualidad es posible medir el flujo sanguíneo de la retina mediante angiografía cuantitativa, basándose en técnicas de dilución de contraste. Con este método puede representarse gráficamente la concentración de contraste fluorescente en la sangre en un punto determinado a lo largo del tiempo, produciendo una curva de dilución de contraste y permitiendo el cálculo de la velocidad de flujo sanguíneo en ese punto. Sin embargo, sin una medida del diámetro vascular correspondiente no es posible determinar el flujo sanguíneo absoluto (que es el parámetro clínicamente relevante, dado que los cambios en la velocidad del flujo sanguíneo pueden suceder en estados no patológicos a causa de los fenómenos de autorregulación retiniana). Además, la naturaleza invasiva de esta administración intravenosa de contraste impide su utilización rutinaria en muchos escenarios clínicos. Por estos motivos se está poniendo mucho énfasis en la aplicación del efecto Doppler en sistemas de OCT para permitir la cuantificación no invasiva del flujo sanguíneo (Figura 7)11.

Figura 7. Doppler OCT. En la retinografía se aprecia el doble anillo de escaneado de la OCT (a). Al comparar la posición relativa de los vasos sanguíneos en las dos secciones de OCT es posible calcular el ángulo Doppler existente entre el rayo del laser de OCT y el vaso (b). Esto permite diferenciar entre arterias y venas en función del cambio en la señal Doppler, como se aprecia en esta representación gráfica en corte único del anillo escaneado. (Fuente: Wang Y, Fawzi AA, Varma R, et al. Pilot study of optical coherence tomography measurement of retinal blood flow in retinal and optic nerve diseases. Invest Ophthalmol Vis Sci. 2011;52(2):840-5).
El efecto Doppler es el cambio en la frecuencia de una onda al ser reflejada en un objeto móvil. Como el cambio en la frecuencia es dependiente de la velocidad del objeto móvil, este efecto puede emplearse para medir la velocidad de la sangre que fluye en la retina. La utilización del efecto Doppler en los sistemas de OCT permite el cálculo de las velocidades del flujo sanguíneo. Si se conoce la velocidad del flujo de la sangre, y puede medirse el diámetro de los vasos sanguíneos mediante imágenes de OCT, entonces es posible determinar valores absolutos de flujo sanguíneo. Desde mediados de la década de 1990, la tecnología Doppler ha sido incorporada en varios prototipos de OCT. Si bien las OCT pueden generar imágenes de cortes (cross-sectional images) del flujo sanguíneo retiniano, la cuantificación precisa de este flujo sigue suponiendo un reto: para poder medirlo de forma fiable es preciso medir la geometría del vaso y, en particular, el ángulo Doppler. Los sistemas de Doppler OCT actuales presentan limitaciones para determinar la máxima velocidad del flujo sanguíneo que se da en los capilares, así como los mínimos diámetros vasculares medibles (dado que el flujo capilar implica movimientos de eritrocitos aislados en vez de flujo continuo de fluido). A pesar de estas limitaciones, una serie de dispositivos comerciales han comenzado a incorporar esta tecnología Doppler (por ejemplo Envisu, Bioptigen). Si bien esta técnica parece muy interesante para evaluar el estado del flujo vascular de la retina, la complejidad de la hemodinámica retiniana hace que sean necesarios amplios estudios de validación de estas técnicas antes de plantear una aplicación clínica real. De hecho, en el pasado, las técnicas Doppler ya fueron evaluadas en sistemas de oftalmoscopia con escaneado laser (SLO) (por ejemplo Heidelberg Retina Flowmeter, HRF) y no obtuvieron un éxito generalizado debido a dudas sobre la precisión de las medidas obtenidas con este método12.
OCT de ojo completo (whole-eye) y OCT binocular
Los dispositivos de OCT clínicos típicamente tienen un rango de escaneo de unos 2 mm y están diseñados para obtener imágenes del segmento posterior (retina, coroides y cabeza del nervio óptico) o de componentes del segmento anterior (córnea, cámara anterior o ángulo iridocorneal). La introducción de la OCT swept-source permite incrementar significativamente este rango de escaneo y capturar todo el segmento anterior en una única imagen (incluyendo el cristalino), e incluso obtener imágenes del ojo completo (este rango de escaneo no es posible con dispositivos de OCT de dominio espectral por la limitación que supone la resolución del espectrómetro). Recientemente se han propuesto unas nuevas fuentes de iluminación con cambio de frecuencia (frequency-swept light sources), denominadas vertical cavity surface emitting lasers (VCSEL), que permiten obtener imágenes con rangos de escaneo de 50 mm y han demostrado ser capaces de ofrecer las primeras imágenes de OCT en tres dimensiones del ojo en su totalidad13.De este modo, las OCT de ojo completo (whole-eye OCT) vienen a representar una auténtica revolución, suponiendo el primer paso hacia una reinvención completa de la exploración ocular mediante OCT, denominada biomicroscopía por OCT (OCT biomicroscopy). Esta técnica permitirá la documentación de la patología del segmento anterior en la córnea, la cámara anterior, el iris y el cristalino, la medida de parámetros biométricos oculares, la obtención de imágenes objetivas y medidas objetivas de progresión de cataratas, la determinación del engrosamiento del cristalino, la determinación de la posición de la lente intraocular y la opacificación de la cápsula posterior, la detección de hallazgos en el vítreo, como inflamación, hemorragia o degeneración asociada a la edad, y la documentación precisa de patología de retina, coroides, esclera o nervio óptico (Figura 8). La aplicación de estas OCT de ojo completo en dispositivos binoculares (a modo de “catalejos”) permitirá que los propios pacientes puedan posicionar el instrumento y alinearlo con sus ojos por sí mismos, permitiendo una funcionalidad extendida (por ejemplo, evaluación de la motilidad ocular, perimetría y pupilometría)14.

Figura 8. OCT de ojo completo (whole-eye OCT). Con la tecnología de OCT de rango ultraprofundo (ultra-long depth range OCT) es posible realizar reconstrucciones en 3D del ojo completo, tanto del segmento anterior (a) como de la mácula, a través del espacio pupilar (b). (Fuente: Grulkowski I, Liu JJ, Potsaid B, et al. Retinal, anterior segment and full eye imaging using ultrahigh speed swept source OCT with vertical-cavity surface emitting lasers. Biomedical Optics Express. 2012;3(11):2733-51). Con los prototipos de OCT binoculares (c), el paciente puede alinear sus ojos con el dispositivo de captura (a modo de “catalejos”), permitiendo una mayor funcionalidad que con los aparatos convencionales. Este prototipo de OCT binocular, desarrollado por el Dr. Alexander Walsh et al, consta de sistema de autofoco, dos pantallas LCD independientes, un microordenador y un sistema de OCT swept-source en miniatura. Como se muestra en esta simulación de OCT de ojo completo (d), por ejemplo, con estos dispositivos podría detectarse la presencia de células en el vítreo (*) y edema macular quístico (flecha) en inflamaciones activas (izquierda), así como la resolución de las mismas tras el tratamiento pertinente (derecha). La incorporación de otras técnicas de exploración (como evaluación de la motilidad ocular, perimetría, pupilometría, etc.) revolucionará la exploración convencional con OCT, para dar paso a la biomicroscopía por OCT. (Fuente: Walsh AC. Binocular optical coherence tomography. Ophthalmic Surg Lasers Imaging. 2011;42(4):S95-S105).
Conclusiones
En los últimos 10 años se ha producido un avance significativo en los sistemas de OCT. Las mejoras técnicas incorporadas progresivamente en los sistemas de OCT desde los primeros aparatos de dominio tiempo y dominio espectral han dado paso a las nuevas generaciones swept-source, ya disponibles comercialmente y en proceso de expansión en la actualidad. El futuro aparece prometedor para los nuevos prototipos que incorporan la OCA, así como los sistemas de OCT portátiles y los OCT intraoperatorios, especialmente aquellos sistemas incorporados al microscopio quirúrgico. La combinación de la tecnología mas avanzada de OCT de rango ultraprofundo y el desarrollo de otras aplicaciones en la exploración oftalmológica dará paso a una nueva generación de dispositivos de OCT binoculares capaces de examinar el ojo completo, que redefinirán el concepto de OCT en la exploración oftalmológica para dar paso a la llamada biomicroscopía por OCT.Conflictos de intereses
El Dr. Javier Zarranz-Ventura ha recibido bolsas de viaje de Allergan y Bayer, y forma parte del European Retina Panel de Allergan. El Dr. Keane ha recibido bolsas de viaje de Allergan, forma parte del European Retina Panel de Allergan, ha participado como Consultor para Novartis y está parcialmente remunerado por el Department of Health’s NIHR Biomedical Research Centre for Ophthalmology en el Moorfields Eye Hospital y UCL Institute of Ophthalmology. Las opiniones expresadas en esta publicación son particulares de este autor y no necesariamente del Department of Health.Bibliografía
- Drexler W, Fujimoto JG. State-of-the-art retinal optical coherence tomography. Progress in Retinal and Eye Research. 2008;27(1):45-88.
- Reznicek L, Klein T, Wieser W, et al. Megahertz ultra-wide-field swept-source retina optical coherence tomography compared to current existing imaging devices. Graefes Arch Clin Exp Ophthalmol. 2014;252(6):1009-16.
- Klein T, Wieser W, Reznicek L, Neubauer A, Kampik A, Huber R. Multi-MHz retinal OCT. Biomedical Optics Express. 2013;4(10):1890-908.
- Keane PA, Ruiz-García H, Sadda SR. Clinical applications of long-wavelength (1,000-nm) optical coherence tomography. Ophthalmic Surg Lasers Imaging. 2011;42(4):S67-74.
- Huang LL, Hirose T. Portable optical coherence tomography in management of vitreoretinal diseases: current developments, indications, and implications. Seminars in Ophthalmology. 2012;27(5-6):213-20.
- Hahn P, Migacz J, O’Donnell R, et al. Preclinical evaluation and intraoperative human retinal imaging with a high-resolution microscope-integrated spectral domain optical coherence tomography device. Retina. 2013;33(7):1328-37.
- Tao YK, Srivastava SK, Ehlers JP. Microscope-integrated intraoperative OCT with electrically tunable focus and heads-up display for imaging of ophthalmic surgical maneuvers. Biomedical Optics Express. 2014;5(6):1877-85.
- Kim DY, Fingler J, Zawadzki RJ, et al. Optical imaging of the chorioretinal vasculature in the living human eye. Proceedings of the National Academy of Sciences of the United States of America. 2013;110(35):14354-9.
- Jia Y, Bailey ST, Wilson DJ, et al. Quantitative optical coherence tomography angiography of choroidal neovascularization in age-related macular degeneration. Ophthalmology. 2014;121(7):1435-44.
- Kurokawa K, Sasaki K, Makita S, Hong YJ, Yasuno Y. Three-dimensional retinal and choroidal capillary imaging by power Doppler optical coherence angiography with adaptive optics. Optics Express. 2012;20(20):22796-812.
- Wang Y, Fawzi AA, Varma R, et al. Pilot study of optical coherence tomography measurement of retinal blood flow in retinal and optic nerve diseases. Invest Ophthalmol Vis Sci. 2011;52(2):840-5.
- Feke GT, Yoshida A, Schepens CL. Laser based instruments for ocular blood flow assessment. Journal of Biomedical Optics. 1998;3(4):415-22.
- Grulkowski I, Liu JJ, Potsaid B, et al. Retinal, anterior segment and full eye imaging using ultrahigh speed swept source OCT with vertical-cavity surface emitting lasers. Biomedical Optics Express. 2012;3(11):2733-51.
- Walsh AC. Binocular optical coherence tomography. Ophthalmic Surg Lasers Imaging. 2011;42(4):S95-S105.


